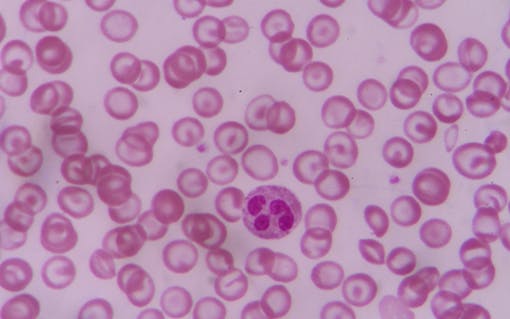
Bloodsmear

Cannabis has been used medicinally for a very long time. People have employed this resinous flower to treat symptoms from minor physical discomfort to epilepsy and arthritis, and now, sickle cell anemia.
What Is Sickle Cell Anemia?
Sickle cell anemia is a blood disease. Healthy blood cells are shaped like donuts without a hole. These disc-shaped organisms are small, but contain our genetic code and, more importantly, our oxygen. Oxygen, as I’m sure you know, is what we breathe, and most times when our oxygen supply is put in jeopardy, so are our lives.
As the name suggests, sickle cell disease changes the shape of these once disc-like cells into that of crescent moons (or sickles). This reshaping makes it very difficult for blood cells’ hemoglobin to hold on to and circulate oxygen, and can also cause blockages in the circulatory system that can have fatal results.
Common symptoms of sickle cell anemia include:
- Shortage of red blood cells, causing anemia
- Bouts of “sickle pain” where congested parts of the circulatory system become swollen and inflamed, eliciting a throbbing/stabbing pain that is only abated by taking medication and/or increasing circulation
- Swelling of hands and feet
- Spleen and internal organ inflammation and damage, which can lead to frequent infections
- Slowed growth and delayed puberty
- Vision problems
- Risk of stroke
What Are Treatment Options for Sickle Cell Anemia?

Currently the only potential cure for sickle cell anemia is a bone marrow transplant. Barring that, treatment options for pain and discomfort include over-the-counter pain relievers, antibiotics for infections, and Hydroxyurea, which is commonly prescribed to leukemia and cancer patients.
For sickle cell patients, Hydroxyurea can help prevent the formation of the sickle-shaped blood cells and reduce pain frequency, although it causes major side effects (nausea, vomiting, loss of appetite, sores, dizziness, diarrhea, hair loss, seizures) and can actually increase risk of infection.
Sickle Cell Statistics

Who is affected by this illness, and how expensive is treatment of sickle cell anemia? Here are some statistics.
- Approximately 100,000 Americans have sickle cell disease.
- Sick cell disease occurs in 1 of 365 black or African American births, and 1 of 16,300 Hispanic births.
- About 1 in 13 black or African American babies are born with a sickle cell trait. If that young person grows up and has a child with another person with a sickle cell trait, the likelihood of a fully formed version of sickle cell is increased by virtue of recessive/dominant traits.
- In 2005, the average medical expenditure for children admitted with sickle cell disease with Medicaid was $11,702, and those with employee-sponsored insurance was $14,772. Forty percent of either of these groups reported at least one visit to the hospital.
How Can Cannabis Help Sickle Cell Patients?

Cannabis may not be a panacea for everyone, but its usefulness and versatility cater to many, including those suffering from sickle cell disease. Alongside the mood enhancing, uplifting, and euphoric effects, cannabis also has analgesic (pain relief) and anti-inflammatory (anti-swelling) properties that are particularly useful for sickle cell patients. These attributes lend themselves to people surviving sickle cell disease.
Unlike over-the-counter pharmaceuticals, a patient can grow this medicine in their home, and medical marijuana offers a strong alternative to the over-prescribed opioids.





